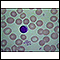

Blood smear
Peripheral smear; Complete blood count - peripheral; CBC - peripheralA blood smear is a blood test that gives information about the number and shape of blood cells. It is often done as part of or along with a complete blood count (CBC).
How the Test is Performed
A blood sample is needed.
Blood sample
Venipuncture is the collection of blood from a vein. It is most often done for laboratory testing.

The blood sample is sent to a lab. There, the lab technician looks at it under a microscope. Or, the blood may be examined by an automated machine.
The smear provides this information:
- The number and kinds of white blood cells (differential, or percentage of each type of cell)
Differential
The blood differential test measures the percentage of each type of white blood cell (WBC) that you have in your blood. It also reveals if there are...
 ImageRead Article Now Book Mark Article
ImageRead Article Now Book Mark Article - The number and kinds of abnormally shaped blood cells
- A rough estimate of white blood cell and platelet counts
How to Prepare for the Test
No special preparation is necessary.
How the Test will Feel
When the needle is inserted to draw blood, some people feel moderate pain. Others feel only a prick or stinging. Afterward, there may be some throbbing or a slight bruise. This soon goes away.
Why the Test is Performed
This test may be done as part of a general health exam to help diagnose many illnesses. Or, your health care provider may recommend this test if you have signs of:
- Any known or suspected blood disorder
- Cancer
- Leukemia
A blood smear may also be done to monitor the side effects of chemotherapy or to help diagnose an infection, such as malaria.
Normal Results
Red blood cells (RBCs) normally are of similar size and color and are a lighter color in the center. The blood smear is considered normal if there is:
- Normal appearance of cells
- Normal white blood cell differential
Normal value ranges may vary slightly among different laboratories. Some labs use different measurements or test different samples. Talk to your provider about the meaning of your specific test results.
What Abnormal Results Mean
Abnormal results mean the size, shape, color, or coating of the RBCs is not normal.
Some abnormalities may be graded on a 4-point scale:
- 1+ means one quarter of cells are affected
- 2+ means one half of cells are affected
- 3+ means three quarters of cells are affected
- 4+ means all of the cells are affected
Presence of cells called target cells may be due to:
- Abnormal hemoglobin, the protein in RBCs that carries oxygen (hemoglobinopathies)
Hemoglobin
Hemoglobin is a protein in red blood cells that carries oxygen. The hemoglobin test measures how much hemoglobin is in your blood.
 ImageRead Article Now Book Mark Article
ImageRead Article Now Book Mark Article - Deficiency of an enzyme called lecithin cholesterol acyltransferase
- Iron deficiency
-
Liver disease
Liver disease
The term "liver disease" applies to many conditions that stop the liver from working or prevent it from functioning well. Abdominal pain or swelling...
 ImageRead Article Now Book Mark Article
ImageRead Article Now Book Mark Article - Spleen removal (splenectomy)
Presence of sphere-shaped cells may be due to:
- Low number of RBCs due to the body destroying them (immune hemolytic anemia)
Immune hemolytic anemia
Anemia is a condition in which the body does not have enough healthy red blood cells. Red blood cells provide oxygen to the body's tissues. Red bloo...
 ImageRead Article Now Book Mark Article
ImageRead Article Now Book Mark Article - Low number of RBCs due to some RBCs shaped like spheres (hereditary spherocytosis)
Hereditary spherocytosis
Hereditary spherocytic anemia is a rare disorder of the surface layer (membrane) of red blood cells. It leads to red blood cells that are shaped lik...
ImageRead Article Now Book Mark Article
ImageRead Article Now Book Mark Article - Increased breakdown of RBCs
Presence of RBCs with an oval shape may be a sign of hereditary elliptocytosis or hereditary ovalocytosis. These are conditions in which RBCs are abnormally shaped.
Hereditary elliptocytosis
Hereditary elliptocytosis is a disorder passed down through families in which the red blood cells are abnormally shaped. It is similar to other bloo...

Hereditary ovalocytosis
Hereditary ovalocytosis is a rare condition passed down through families (inherited). The blood cells are oval-shaped instead of round. It is a for...

Presence of fragmented cells (also called schistocytes) may be due to:
- Artificial heart valve
- Blood disorder that causes blood clots to form in small blood vessels around the body and leads to a low platelet count (thrombotic thrombocytopenic purpura)
Thrombotic thrombocytopenic purpura
Thrombotic thrombocytopenic purpura (TTP) is a blood disorder in which platelet clumps form in small blood vessels. This leads to a low platelet cou...
 ImageRead Article Now Book Mark Article
ImageRead Article Now Book Mark Article - Disorder in which the proteins that control blood clotting become overactive (disseminated intravascular coagulation)
Disseminated intravascular coagulation
Disseminated intravascular coagulation (DIC) is a serious disorder in which the proteins that control blood clotting become overactive.
 ImageRead Article Now Book Mark Article
ImageRead Article Now Book Mark Article - Infection in the digestive system producing toxic substances that destroy RBCs, causing kidney injury (hemolytic uremic syndrome)
Hemolytic uremic syndrome
Shiga-like toxin producing E coli hemolytic-uremic syndrome (STEC-HUS) is a disorder that most often occurs when an infection in the digestive system...
 ImageRead Article Now Book Mark Article
ImageRead Article Now Book Mark Article
Presence of a type of immature RBCs called normoblasts may be due to:
- Blood disorder called erythroblastosis fetalis that affects a fetus or newborn
Erythroblastosis fetalis
Hemolytic disease of the newborn (HDN) is a blood disorder in a fetus or newborn infant. In some infants, it can be fatal. Normally, red blood cells...
 ImageRead Article Now Book Mark Article
ImageRead Article Now Book Mark Article - Cancer that has spread to bone marrow
- Disorder in which there is excessive breakdown of hemoglobin (thalassemia)
Thalassemia
Thalassemia is a blood disorder passed down through families (inherited) in which the body makes an abnormal form or inadequate amount of hemoglobin....
 ImageRead Article Now Book Mark Article
ImageRead Article Now Book Mark Article - Disorder of the bone marrow in which the marrow is replaced by fibrous scar tissue (myelofibrosis)
Myelofibrosis
Myelofibrosis is a disorder of the bone marrow in which the marrow is replaced by fibrous scar tissue.
Read Article Now Book Mark Article - Removal of spleen (splenectomy)
- Severe breakdown of RBCs (hemolysis)
- Tuberculosis that has spread from the lungs to other parts of the body through the blood (miliary tuberculosis)
Miliary tuberculosis
Disseminated tuberculosis is a mycobacterial infection in which mycobacteria spread from the lungs to other parts of the body through the blood or ly...
 ImageRead Article Now Book Mark Article
ImageRead Article Now Book Mark Article
The presence of cells called burr cells may indicate:
- Abnormally high level of nitrogen waste products in the blood (uremia)
Uremia
Prerenal azotemia is an abnormally high level of nitrogen waste products in the blood.
 ImageRead Article Now Book Mark Article
ImageRead Article Now Book Mark Article
The presence of cells called spur cells may indicate:
- Inability to fully absorb dietary fats through the intestines (abetalipoproteinemia)
Abetalipoproteinemia
Bassen-Kornzweig syndrome is a rare disease passed down through families. The person is unable to fully absorb dietary fats through their intestines...
Read Article Now Book Mark Article - Severe liver disease
The presence of teardrop-shaped cells may indicate:
- Anemia caused by bone marrow not producing normal blood cells due to toxins or tumor cells (myelophthisic process)
- Cancer in the bone marrow
- Myelofibrosis
- Severe iron deficiency
- Thalassemia major
The presence of Howell-Jolly bodies (a type of granule inside the red blood cells) may indicate:
- Bone marrow does not produce enough healthy blood cells (myelodysplasia)
-
Sickle cell anemia
Sickle cell anemia
Sickle cell disease is a disorder passed down through families. The red blood cells that are normally shaped like a disk take on a sickle or crescen...
 ImageRead Article Now Book Mark Article
ImageRead Article Now Book Mark Article -
Spleen has been removed (splenectomy)
Spleen has been removed
Spleen removal is surgery to remove a diseased or damaged spleen. This surgery is called splenectomy. The spleen is in the upper part of the belly, ...
 ImageRead Article Now Book Mark Article
ImageRead Article Now Book Mark Article
The presence of Heinz bodies (bits of altered hemoglobin) may indicate:
- Alpha thalassemia
- Congenital hemolytic anemia
- Disorder in which RBCs break down when the body is exposed to certain medicines or is stressed because of infection (G6PD deficiency)
G6PD deficiency
Glucose-6-phosphate dehydrogenase (G6PD) deficiency is a condition in which red blood cells break down when the body is exposed to certain medicines ...
 ImageRead Article Now Book Mark Article
ImageRead Article Now Book Mark Article - Unstable form of hemoglobin
The presence of slightly immature RBCs may indicate:
- Anemia with bone marrow recovery
- Hemolytic anemia
- Hemorrhage
The presence of basophilic stippling (a spotted appearance) may indicate:
- Disorder of the bone marrow in which the marrow is replaced by fibrous scar tissue (myelofibrosis)
-
Lead poisoning
Lead poisoning
Lead is a very strong poison. When a person swallows an object that has lead in it or breathes in lead dust, some of the poison can stay in the body...
Read Article Now Book Mark Article
The presence of sickle cells may indicate sickle cell anemia.
Risks
There is little risk involved with having your blood taken. Veins and arteries vary in size from one patient to another and from one side of the body to the other. Obtaining a blood sample from some people may be more difficult than from others.
Other risks associated with having blood drawn are slight, but may include:
- Excessive bleeding
- Fainting or feeling lightheaded
- Multiple punctures to locate veins
- Hematoma (blood buildup under the skin)
- Infection (a slight risk any time the skin is broken)
References
Bain BJ. The peripheral blood smear. In: Goldman L, Cooney KA, eds. Goldman-Cecil Medicine. 27th ed. Philadelphia, PA: Elsevier; 2024:chap 143.
Lim HI, Lee A. Peripheral blood smear. In: Leppert BC, Kelly CR, eds. Netter's integrated review of medicine: pathogens to treatment. Philadelphia, PA: Elsevier; 2021:chap 40.
Prozora S, Gallagher PG. Hereditary elliptocytosis, hereditary pyropoikilocytosis, and related disorders. In: Kliegman RM, St. Geme JW, Blum NJ, et al, eds. Nelson Textbook of Pediatrics. 22nd ed. Philadelphia, PA: Elsevier; 2025:chap 508.
Thom CS, Lambert MP. Blood disorders. In: Kliegman RM, St. Geme JW, Blum NJ, et al, eds. Nelson Textbook of Pediatrics. 22nd ed. Philadelphia, PA: Elsevier; 2025:chap 138.
-
Red blood cells, sickle cell - illustration
Sickle cell anemia is an inherited blood disease in which the red blood cells produce abnormal pigment (hemoglobin). The abnormal hemoglobin causes deformity of the red blood cells into crescent or sickle-shapes, as seen in this photomicrograph.
Red blood cells, sickle cell
illustration
-
Red blood cells, tear-drop shape - illustration
This photomicrograph shows one of the abnormal shapes that red blood cells (RBCs) may assume, a tear-drop shape. Normally, RBCs are round.
Red blood cells, tear-drop shape
illustration
-
Red blood cells - normal - illustration
This photomicrograph shows normal red blood cells (RBCs) as seen in the microscope after staining.
Red blood cells - normal
illustration
-
Red blood cells - elliptocytosis - illustration
Elliptocytosis is a hereditary disorder of the red blood cells (RBCs). In this condition, the RBCs assume an elliptical shape, rather than the typical round shape.
Red blood cells - elliptocytosis
illustration
-
Red blood cells - spherocytosis - illustration
Spherocytosis is a hereditary disorder of the red blood cells (RBCs), which may be associated with a mild anemia. Typically, the affected RBCs are small, spherically shaped, and lack the light centers seen in normal, round RBCs.
Red blood cells - spherocytosis
illustration
-
Acute lymphocytic leukemia - photomicrograph - illustration
This picture shows the darkly-stained lymph cells (lymphoblasts) seen in acute lymphocytic leukemia (ALL), the most common type of childhood leukemia.
Acute lymphocytic leukemia - photomicrograph
illustration
-
Red blood cells - multiple sickle cells - illustration
Sickle cell anemia is an inherited disorder in which abnormal hemoglobin (the red pigment inside red blood cells) is produced. The abnormal hemoglobin causes red blood cells to assume a sickle shape, like the ones seen in this photomicrograph.
Red blood cells - multiple sickle cells
illustration
-
Malaria, microscopic view of cellular parasites - illustration
Malarial parasites are visible within the red blood cells. They are stained a dark bluish color.
Malaria, microscopic view of cellular parasites
illustration
-
Malaria, photomicrograph of cellular parasites - illustration
Malaria is a disease caused by parasites. This picture shows dark orange-stained malaria parasites inside red blood cells (a) and outside the cells (b). Note the large cells that look like targets; it is unknown how these target cells are related to this disease.
Malaria, photomicrograph of cellular parasites
illustration
-
Red blood cells - sickle cells - illustration
These crescent or sickle-shaped red blood cells (RBCs) are present with Sickle cell anemia, and stand out clearly against the normal round RBCs. These abnormally shaped cells may become entangled and block blood flow in the small blood vessels (capillaries).
Red blood cells - sickle cells
illustration
-
Red blood cells - sickle and Pappenheimer - illustration
This photomicrograph of red blood cells (RBCs) shows both sickle-shaped and Pappenheimer bodies.
Red blood cells - sickle and Pappenheimer
illustration
-
Red blood cells, target cells - illustration
These abnormal red blood cells (RBCs) resemble targets. These cells are seen in association with some forms of anemia, and following the removal of the spleen (splenectomy).
Red blood cells, target cells
illustration
-
Formed elements of blood - illustration
Blood transports oxygen and nutrients to body tissues and returns waste and carbon dioxide. Blood distributes nearly everything that is carried from one area in the body to another place within the body. For example, blood transports hormones from endocrine organs to their target organs and tissues. Blood helps maintain body temperature and normal pH levels in body tissues. The protective functions of blood include clot formation and the prevention of infection.
Formed elements of blood
illustration
-
Red blood cells, sickle cell - illustration
Sickle cell anemia is an inherited blood disease in which the red blood cells produce abnormal pigment (hemoglobin). The abnormal hemoglobin causes deformity of the red blood cells into crescent or sickle-shapes, as seen in this photomicrograph.
Red blood cells, sickle cell
illustration
-
Red blood cells, tear-drop shape - illustration
This photomicrograph shows one of the abnormal shapes that red blood cells (RBCs) may assume, a tear-drop shape. Normally, RBCs are round.
Red blood cells, tear-drop shape
illustration
-
Red blood cells - normal - illustration
This photomicrograph shows normal red blood cells (RBCs) as seen in the microscope after staining.
Red blood cells - normal
illustration
-
Red blood cells - elliptocytosis - illustration
Elliptocytosis is a hereditary disorder of the red blood cells (RBCs). In this condition, the RBCs assume an elliptical shape, rather than the typical round shape.
Red blood cells - elliptocytosis
illustration
-
Red blood cells - spherocytosis - illustration
Spherocytosis is a hereditary disorder of the red blood cells (RBCs), which may be associated with a mild anemia. Typically, the affected RBCs are small, spherically shaped, and lack the light centers seen in normal, round RBCs.
Red blood cells - spherocytosis
illustration
-
Acute lymphocytic leukemia - photomicrograph - illustration
This picture shows the darkly-stained lymph cells (lymphoblasts) seen in acute lymphocytic leukemia (ALL), the most common type of childhood leukemia.
Acute lymphocytic leukemia - photomicrograph
illustration
-
Red blood cells - multiple sickle cells - illustration
Sickle cell anemia is an inherited disorder in which abnormal hemoglobin (the red pigment inside red blood cells) is produced. The abnormal hemoglobin causes red blood cells to assume a sickle shape, like the ones seen in this photomicrograph.
Red blood cells - multiple sickle cells
illustration
-
Malaria, microscopic view of cellular parasites - illustration
Malarial parasites are visible within the red blood cells. They are stained a dark bluish color.
Malaria, microscopic view of cellular parasites
illustration
-
Malaria, photomicrograph of cellular parasites - illustration
Malaria is a disease caused by parasites. This picture shows dark orange-stained malaria parasites inside red blood cells (a) and outside the cells (b). Note the large cells that look like targets; it is unknown how these target cells are related to this disease.
Malaria, photomicrograph of cellular parasites
illustration
-
Red blood cells - sickle cells - illustration
These crescent or sickle-shaped red blood cells (RBCs) are present with Sickle cell anemia, and stand out clearly against the normal round RBCs. These abnormally shaped cells may become entangled and block blood flow in the small blood vessels (capillaries).
Red blood cells - sickle cells
illustration
-
Red blood cells - sickle and Pappenheimer - illustration
This photomicrograph of red blood cells (RBCs) shows both sickle-shaped and Pappenheimer bodies.
Red blood cells - sickle and Pappenheimer
illustration
-
Red blood cells, target cells - illustration
These abnormal red blood cells (RBCs) resemble targets. These cells are seen in association with some forms of anemia, and following the removal of the spleen (splenectomy).
Red blood cells, target cells
illustration
-
Formed elements of blood - illustration
Blood transports oxygen and nutrients to body tissues and returns waste and carbon dioxide. Blood distributes nearly everything that is carried from one area in the body to another place within the body. For example, blood transports hormones from endocrine organs to their target organs and tissues. Blood helps maintain body temperature and normal pH levels in body tissues. The protective functions of blood include clot formation and the prevention of infection.
Formed elements of blood
illustration
Review Date: 3/11/2024
Reviewed By: Frank D. Brodkey, MD, FCCM, Associate Professor, Section of Pulmonary and Critical Care Medicine, University of Wisconsin School of Medicine and Public Health, Madison, WI. Also reviewed by David C. Dugdale, MD, Medical Director, Brenda Conaway, Editorial Director, and the A.D.A.M. Editorial team.














